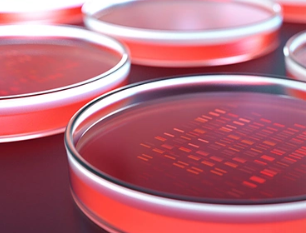
image.png

海南新生兒干細胞存儲費用多少,性價比如何
2024-12-07 15:43:13 來源: 小編 咨詢醫(yī)生
隨著醫(yī)學科技的不斷發(fā)展,新生兒干細胞存儲成為越來越多家庭關注的焦點。本文將圍繞“海南新生兒干細胞存儲費用多少,性價比如何”這一主題,為您詳細解析新生兒干細胞存儲的相關問題。
一、新生兒干細胞存儲的費用分析
新生兒干細胞存儲的費用包括采集、檢測、處理、冷凍等多個環(huán)節(jié)。在海南地區(qū),新生兒干細胞存儲的費用大致可分為以下幾個部分:
1.采集費用:通常情況下,新生兒干細胞采集費用在2000-3000元人民幣之間。
2.檢測費用:包括樣本檢測、細胞活性檢測等,費用約為1000-2000元人民幣。
3.處理費用:包括細胞的分離、純化、凍存等,費用約為2000-3000元人民幣。
4.冷凍費用:干細胞凍存費用根據(jù)存儲年限不同而有所差異,通常每年的費用在1000-2000元人民幣。
綜合以上費用,新生兒干細胞存儲的總費用約為5000-8000元人民幣。
二、性價比分析
新生兒干細胞存儲的性價比取決于以下幾個方面:
1.潛在的治療價值:新生兒干細胞具有多能分化潛能,可以用于治療多種疾病,如血液病、神經(jīng)系統(tǒng)疾病等。隨著醫(yī)學技術的不斷進步,干細胞治療的應用領域?qū)⒃絹碓綇V泛。
2.自體移植優(yōu)勢:使用新生兒干細胞進行自體移植,避免了免疫排斥反應,提高了治療成功率。
3.長期存儲的安全性:現(xiàn)代冷凍技術可以確保干細胞在長期存儲過程中保持活性,為未來可能的治療提供保障。
4.家庭健康管理:存儲新生兒干細胞可以為家庭健康管理提供一種保障,增加家庭對疾病的抵抗能力。
三、結(jié)論
從費用和性價比來看,海南新生兒干細胞存儲具有較高的性價比。雖然初期投入相對較高,但考慮到其潛在的治療價值和家庭健康管理意義,這一投資是值得的。在選擇干細胞存儲服務時,家長應綜合考慮服務機構(gòu)的信譽、技術實力和存儲條件等因素,確保新生兒干細胞的安全存儲。在醫(yī)學科技不斷發(fā)展的今天,新生兒干細胞存儲為我們帶來了更多希望和可能性。家庭在做出決策時,應充分了解相關信息,權(quán)衡利弊,為孩子的未來提供更多保障。
- 2024-10-14天津牙髓干細胞存儲哪家機構(gòu)更專業(yè)?如何選擇最佳存儲方案?
- 2024-10-31鄭州干細胞存儲機構(gòu)在哪里有?主要有什么存儲方法?
- 2024-09-16無錫人體干細胞存儲公司,內(nèi)附機構(gòu)名單
- 2024-11-05干細胞存儲能否分期付款?
- 2024-07-27存儲臍帶間充質(zhì)干細胞,存儲臍帶間充質(zhì)干細胞的方法
- 2024-10-29華陰干細胞存儲費用詳解,哪家機構(gòu)更實惠?
- 2024-10-10天津干細胞價格貴嗎?如何選擇性價比高的治療?
- 2024-08-06存儲臍帶質(zhì)干細胞,臍帶間充質(zhì)干細胞儲存費用
- 2024-09-24干細胞種植頭發(fā)全過程,干細胞植發(fā)技術成熟嗎
- 2024-08-02做干細胞移植要多少錢,做干細胞移植手術有風險嗎
- 2024-09-06干細胞治療貓口炎效果好嗎多少錢
- 2024-09-04干細胞制備新技術的優(yōu)勢及應用前景
- 2024-09-27廣州貝拉醫(yī)療對腫瘤有用嗎
- 2024-08-26廣東干細胞機構(gòu)有哪些,廣東干細胞機構(gòu)名單公布
- 2024-09-27造血干細胞儲存流程復雜嗎?哪些機構(gòu)提供儲存服務?
- 2024-09-05多能干細胞技術治療原理,帶你揭開它的神秘面紗
- 2024-09-05帕金森干細胞療法多少錢,什么醫(yī)院可以做
- 2024-10-11干細胞移植后需要留意哪些細節(jié)?哪些醫(yī)院提供此類服務?
